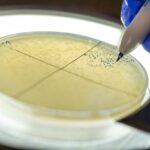
viral-srna-unlocks-phage-therapy-potential-against-drug-resistant-bacteria

In a groundbreaking advance poised to transform cardiovascular research, scientists have harnessed the power of single-cell spatial transcriptomics to unravel the intricate morphological and molecular heterogeneity present within atherosclerotic carotid arteries. This innovative study, recently published in Nature Communications, represents a vital leap forward in our understanding of atherosclerosis—a chronic inflammatory disease underpinning much of the global burden of stroke and heart attack. By seamlessly integrating spatial context with cellular transcriptomic data at an unprecedented resolution, the research team led by Pauli, Garger, and Peymani has opened new avenues to demystify the complex microenvironmental architecture of diseased arteries.
The carotid arteries, critical conduits supplying blood to the brain, are frequent sites where atherosclerotic plaques develop. These plaques, characterized by buildup of lipids, inflammatory cells, and fibrous tissue, are notoriously heterogeneous—not only among different patients, but also within different regions of the same artery. Traditional histological techniques lack the resolution to fully capture this cellular diversity and its spatial arrangement, obstructing efforts to identify key pathogenic processes or therapeutic targets. The new study leverages the cutting edge of molecular biology: single-cell RNA sequencing coupled with spatial transcriptomics, a technique that preserves the physical location of each individual cell’s gene expression within tissue slices.
At the heart of the investigation lies the integration of comprehensive spatial gene expression maps with morphological data derived from carotid artery samples exhibiting varying stages of atherosclerosis. Employing state-of-the-art computational frameworks, the researchers systematically reconstructed the cellular neighborhoods that define plaque architecture. This integrative approach revealed striking heterogeneity in cell populations ranging from lipid-laden macrophages to vascular smooth muscle cells, endothelial cells, and rare immune subsets. More importantly, spatial dependencies in gene expression underscored novel interactions that likely influence plaque stability and vulnerability.
One of the striking revelations of the study is how spatial transcriptomics enables the delineation of discrete cellular niches within the atherosclerotic plaque. For instance, clusters of inflammatory macrophages expressing high levels of pro-inflammatory mediators were spatially confined to regions adjacent to necrotic cores. In contrast, smooth muscle cells expressing reparative and fibrotic genes aggregated in regions contributing to fibrous caps, structures critical for preventing plaque rupture. Such spatially resolved molecular insights were previously unachievable and underscore the nuanced and dynamic interplay between cell types influencing disease progression.
Moreover, the team uncovered that gene expression signatures vary not only between distinct cell types but also within individual subpopulations depending on their spatial positioning in the artery wall. This spatial heterogeneity affects pathways governing inflammation, extracellular matrix remodeling, and lipid metabolism—factors that collectively determine whether a plaque remains stable or progresses to rupture, often leading to catastrophic clinical events. By precisely mapping these molecular gradients, the study offers a molecular atlas that can guide targeted interventions aimed at modifying plaque behavior.
Beyond static snapshots, the integration of spatial and single-cell transcriptomics also hints at temporal evolution in plaque morphology. The researchers identified transitional cellular states that likely represent stages of activation or differentiation as cells respond to microenvironmental cues in ischemic and inflamed vascular tissue. This capability to infer trajectory and plasticity from spatially anchored transcriptomes provides a powerful framework for understanding how atherosclerotic plaques evolve over time, and which cellular players might be modulated to halt or reverse disease progression.
The technical sophistication employed in this study has broad implications for the field of spatial biology. By combining advanced tissue preservation, histological staining, and in situ sequencing technologies, the team overcame significant challenges related to spatial resolution, transcriptome coverage, and data integration. Computational pipelines incorporating machine learning and network analysis were critical to decode the massive datasets generated, enabling the identification of spatial gene expression patterns that correlate with morphological features extracted from high-definition imaging. Such multidisciplinary synergy exemplifies the future of precision medicine studies.
Clinically, these insights could revolutionize diagnostic and therapeutic strategies for atherosclerosis. Current imaging modalities used to assess plaque morphology, such as ultrasound and MRI, lack molecular specificity and cannot reveal the underlying cellular states driving plaque vulnerability. The molecular and spatial signatures identified in this research could serve as biomarkers for high-risk plaques or inform the development of novel therapeutics designed to stabilize plaques by modulating specific cell populations or pathways. This precision approach could reduce stroke incidence by enabling early, targeted intervention on “at-risk” plaques before catastrophic rupture.
The study also holds promise for enabling personalized medicine approaches. With spatial transcriptomics, it becomes conceivable to generate individualized maps of plaque biology for patients undergoing carotid endarterectomy or other surgical interventions. Such detailed molecular phenotyping could facilitate tailored treatment decisions and improved prognostic accuracy, moving beyond the “one-size-fits-all” paradigm in cardiovascular care. Moreover, the technology can be extended to study other vascular beds prone to atherosclerosis, potentially broadening its impact across multiple vascular diseases.
Importantly, the work highlights that atherosclerosis is not merely a disease of lipid accumulation but a highly orchestrated multicellular process involving immune responses, tissue remodeling, and cellular crosstalk within precise spatial confines. By illuminating this complexity, the study challenges researchers to rethink therapeutic strategies that traditionally focused only on lipid lowering or broad immunosuppression. Instead, future treatments might aim to recalibrate the spatial cellular ecosystem within plaques, targeting specific pathological niches while preserving protective mechanisms.
In the context of basic science, this research is a tour de force that exemplifies the value of spatially resolved omics to dissect disease mechanisms. It sets a new standard for studies of complex tissue architecture in health and disease, inspiring analogous research in cancer, neurodegeneration, and developmental biology. The integration of single-cell resolution with spatial context is rapidly emerging as an indispensable tool in biomedical research, bridging the gap between molecular detail and physiological tissue organization.
From a technological standpoint, the authors’ methodology is a showcase of innovation. The precise preservation of tissue morphology while capturing full transcriptomes, coupled with computational integration strategies, sets a benchmark for future studies. Their pipeline can be adapted to diverse tissues and diseases, accelerating discovery and translational efforts globally. The study also underscores the importance of interdisciplinary collaboration among molecular biologists, bioinformaticians, pathologists, and clinicians, necessary to translate complex data into meaningful biological and clinical insights.
Looking forward, the insights gleaned from this study pave the way for exciting new research directions. Further exploration of how spatial cellular dynamics change in response to therapies, lifestyle factors, or co-morbidities will be invaluable. The ability to perform longitudinal spatial transcriptomic analyses on serial biopsies or animal models could uncover novel mechanisms of disease remission or exacerbation. Ultimately, integrating spatial multi-omics modalities—transcriptomics, epigenomics, proteomics—will enhance our understanding of atherosclerosis at unprecedented biological depth.
In summary, the work by Pauli, Garger, Peymani, and colleagues represents a monumental step in cardiovascular research. By decoding the spatial and molecular heterogeneity of atherosclerotic carotid arteries at single-cell resolution, they illuminate the cellular choreography underlying disease progression, opening a new frontier for diagnostics, therapeutics, and personalized medicine. As spatial transcriptomics technologies continue to evolve and scale, their impact on understanding and combating atherosclerosis and beyond will only grow more profound, heralding a new era of vascular biology.
Subject of Research: Investigation of the morphological and molecular heterogeneity of atherosclerotic carotid arteries through single-cell spatial transcriptomics integration.
Article Title: Single cell spatial transcriptomics integration deciphers the morphological heterogeneity of atherosclerotic carotid arteries.
Article References:
Pauli, J., Garger, D., Peymani, F. et al. Single cell spatial transcriptomics integration deciphers the morphological heterogeneity of atherosclerotic carotid arteries. Nat Commun (2025). https://doi.org/10.1038/s41467-025-67679-4
Image Credits: AI Generated
Tags: advanced histological techniquesatherosclerotic plaque diversitycardiovascular disease researchcarotid artery atherosclerosiscellular transcriptomic data integrationinflammatory disease mechanismsinnovative cardiovascular research methodsmicroenvironmental architecture of arteriesmolecular heterogeneity in arteriessingle-cell transcriptomicsspatial transcriptomics technologystroke and heart attack risk factors